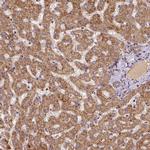
MTCO1 Antibody in Immunohistochemistry (IHC)

Search
Invitrogen
MTCO1 Polyclonal Antibody
{{$productOrderCtrl.translations['antibody.pdp.commerceCard.promotion.promotions']}}
{{$productOrderCtrl.translations['antibody.pdp.commerceCard.promotion.viewpromo']}}
{{$productOrderCtrl.translations['antibody.pdp.commerceCard.promotion.promocode']}}: {{promo.promoCode}} {{promo.promoTitle}} {{promo.promoDescription}}. {{$productOrderCtrl.translations['antibody.pdp.commerceCard.promotion.learnmore']}}
产品信息
PA5-64411
种属反应
宿主/亚型
分类
类型
抗原
偶联物
形式
浓度
规格
纯化类型
保存液
内含物
保存条件
运输条件
RRID
产品详细信息
Immunogen sequence: LIRAELGQPG NLLGNDHIYN VIV
Highest antigen sequence identity to the following orthologs: Mouse - 87%, Rat - 87%.
靶标信息
Cytochrome c oxidase subunit I (CO1 or MTCO1) is 1 of 3 mitochondrial DNA (mtDNA) encoded subunits (MTCO1, MTCO2, MTCO3) of respiratory Complex IV. Complex IV is located within the mitochondrial inner membrane and is the third and final enzyme of the electron transport chain of mitochondrial oxidative phosphorylation. It is composed of 13 polypeptides. Subunits I, II, and III (MTCO1, MTCO2, MTCO3) are encoded by mtDNA while subunits IV, Va, Vb, VIa, VIb, VIc, VIIa, VIIb, VIIc, and VIII are nuclear encoded. The cytochrome c oxidase family of enzymes have 4 redox centers, 2 hemes and 2 copper centers. In mitochondrial Complex IV, the 2 hemes are a and a3 and the 2 coppers are CuA and CuB. The 2 hemes and CuB are bound to subunit I. Acin-Perez et al. (2003) identified a cell line containing single and double missense mutations in the cytochrome c oxidase (COX) subunit I gene of mouse mitochondrial DNA. And they hypothesized that deleterious mutations can arise and become predominant; cultured cells can maintain several mtDNA haplotypes at stable frequencies; the respiratory chain has little spare COX capacity; and that the size of a cavity in the vicinity of val421 in MTCO1I of animal COX may affect the function of the enzyme.
仅用于科研。不用于诊断过程。未经明确授权不得转售。
篇参考文献 (0)
生物信息学
蛋白别名: Co1